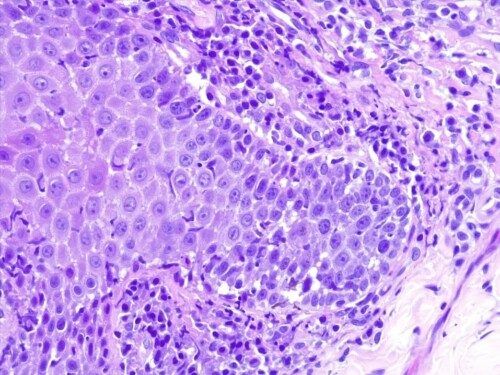

Une femelle Colley de 5 ans est adressée en consultation référée de dermatologie pour la présence de croûtes et de zones dépigmentées sur la truffe, qui s’aggravent depuis 3 mois.
Estelle Buendia, DVM
Janvier 2025
Résumé
Un pemphigus érythémateux a été diagnostiqué chez un Collie de 5 ans, présentant des lésions croûteuses et dépigmentées localisées sur la truffe et le museau dorsal depuis 4 mois. Le diagnostic a été posé sur la base d’informations historiques, de signes cliniques et de la mise en évidence de kératinocytes acantholytiques et d’une dermatite d’interface lichénoïde sur des biopsies cutanées. Un traitement dermocorticoïde à base de pommade au propionate de clobétasol à 0,05 %, remplacé lors de la rémission clinique par une pommade au tacrolimus à 0,1 %, a permis d’obtenir une rémission complète et durable. Une rechute est survenue un an après la présentation initiale en raison de l’absence de protection solaire.
Cas clinique
Les traitements successifs à base d’amoxicilline – acide clavulanique, de crème à l’éconazole et d’acéponate d’hydrocortisone n’ont pas apporté d’amélioration. Une culture mycologique In-Tray® a été réalisée pendant le traitement à l’éconazole et s’est révélée négative.
Elle vit dans une maison avec jardin, sans congénère ni contagiosité évidente. Elle n’avait jamais voyagé à l’étranger et n’a aucun d’antécédent dermatologique.
À l’examen clinique dermatologique, elle présente des zones érythémateuses, alopéciques, dépigmentées et fortement croûteuses sur le planum nasal dorsal. Les croûtes sont épaisses, adhérentes et recouvrent des érosions. Les narines sont dépigmentées et ont partiellement perdu leur architecture de surface normale.
Les lésions sont modérément prurigineuses.


Figure 1 : Nez croûteux et dépigmenté.
Le diagnostic différentiel comprend une dermatophytose, un pemphigus foliacé, un pemphigus érythémateux, un lupus érythémateux discoïde et une pyodermite des jonctions cutanéomuqueuses.
Les hypothèses les plus probables sont une maladie à médiation immunitaire telle que le pemphigus superficiel (foliacé ou érythémateux) et le lupus érythémateux discoïde. La dermatophytose peut provoquer des lésions similaires, en fonction du dermatophyte. Des pustules doivent être observées et concernent principalement la peau poilue, mais le planum nasal peut également être touché.
L’examen cytologique des frottis d’impression des lésions croûteuses a révélé la présence de neutrophiles à divers degrés de dégénérescence, associés à des cocci intracellulaires et extracellulaires.
Une culture fongique réalisée dans un laboratoire mycologique et après l’arrêt de tout traitement antifongique depuis plusieurs semaines, s’est révélée négative.
Sur la base de ces résultats, une maladie cutanée à médiation immunitaire associée à une pyodermite superficielle a été considérée comme le diagnostic le plus probable.
Trois biopsies cutanées de 6 mm ont été prélevées sous anesthésie générale (7 µg/kg de médétomidine (Dormilan® ; Axience, Pantin, France) et 0,3 mg/kg de butorphanol par voie intravasculaire (Torphadine® ; Dechra Veterinary Products, Montigny-le-Bretonneux, France) sur des lésions croûteuses. Les échantillons de biopsie cutanée ont été placés dans du formol. Avant les biopsies, le chien a été traité par voie orale pendant 20 jours avec de la céfalexine à 15 mg/kg deux fois par jour (Rilexine®, Virbac, Carros, France).
L’examen histologique des coupes de lésions croûteuses colorées à l’hématoxyline et à l’éosine révèle une hyperplasie parakératosique, avec de petites vésiculo-pustules intra-épidermiques contenant des éosinophiles et quelques cellules épithéliales acantholysées, un infiltrat lichénoïde avec des lymphocytes, des plasmocytes, des macrophages, des cellules dendritiques et des mélanophages dans les machons péri-annexiels. Aucun élément bactérien ou parasitaire n’est observé.
Figure 2: Photomicrographie. Vésiculo-pustules intra-épidermiques (¤) contenant des éosinophiles et quelques cellules épithéliales acantholysées, et un infiltrat lichénoïde (*) (H&E, x100). (H&E, x100)
Figure 3: Agrandissement plus important. Vésiculo-pustules intra-épidermiques contenant des éosinophiles et quelques cellules épithéliales acantholysées (H&E x400).
Figure 4: Agrandissement plus important. Un infiltrat lichénoïde (Figure 3) formé de lymphocytes, de plasmocytes, de macrophages, de cellules dendritiques et de mélanophages (H&E x400).
Cet aspect histologique a révélé une dermatite micro-pustuleuse granulocytaire intra-épidermique acantholytique et amicrobienne et des lésions de dermatite d’interface lymphocytaire. Cette association lésionnelle de dermatite lichénoïde d’interface et de dermatite pustuleuse acantholytique est caractéristique en dermatologie vétérinaire d’une forme rare de pemphigus superficiel présentant les caractéristiques du lupus érythémateux cutané chronique : le pemphigus érythémateux.
L’examen histopathologique et cytologique combiné aux signes cliniques a permis de poser le diagnostic de pemphigus érythémateux associé à une folliculite bactérienne.
Références
|
1. |
Miller W, Griffin C, Campbell K. Muller and Kirk’s Small Animal Dermatology (7e édition) : Elsevier ; 2012. |
|
2. |
Olivry T. Revue des maladies cutanées auto-immunes des animaux domestiques : I – Le pemphigus superficiel. Vet Dermatol. 2006;17:291-305. |
|
3. |
Scott D, Miller W. Pemphigus erythematosus in the dog and cat. J Am Anim Hosp Assoc. 1980;16:815. |
|
4. |
Gross T, Ihrke P, Walder E, Affolter V. Skin Diseases of the Dog and Cat. Diagnostic clinique et histopathologique : Blackwell Science ; 2005. |
|
5. |
Stevens C, Lempert N, Freed B. The effects of immunosuppressive agents on in vitro production of human immunoglobulins. Transplantation. 1991;51:1240-1244. |
|
6. |
Griffies J, Mendelsohn C, Rosenkrantz WS, et al. Topical 0.1% tacrolimus for the treatment of discoid lupus erythematosus and pemphigus erythematosus in dogs. Journal of the American Animal Hospital Association. 2004;40:29-41. |
|
7. |
Gonsalves-Hubers T. Pemphigus erythematosus in a chow chow. Can Vet J. 2005;46:925-927. |
|
8. |
Iwasaki T, Maeda Y. The effect of ultraviolet on the severity of canine pemphigus erythematosus (Résumé). Paper presented at : American Academy of Veterinary Dermatology and American College of Veterinary Dermatology Annual Meeting, 1997 ; Nashville. |